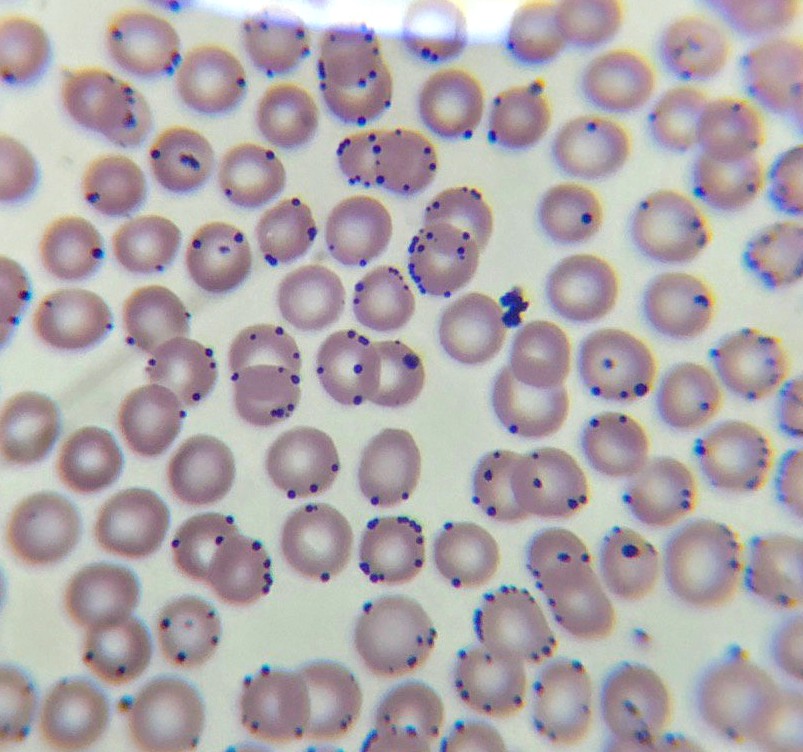

Son parásitos oportunistas que viven a expensas de nosotros, cada que nuestro sistema inmune es debilitado aprovechan a reproducirse y parasitar la mayor cantidad de células. En este caso la mayoría afecta a los glóbulos rojos secuestrándolos y privándolos de su movilidad.
Todas provocan bronquiolitis, como ya lo mencioné si la OMS dice que es neumonía hay que intubar al paciente.
Pero en una bronquiolitis se trata de evitar la ventilación invasiva (intubacion) y se procura usar presión positiva continua (CPAP).
¿Por qué?
Pero en una bronquiolitis se trata de evitar la ventilación invasiva (intubacion) y se procura usar presión positiva continua (CPAP).
¿Por qué?
Porque si decides intubar endotraquealmente a paciente sin datos de neumonía, provocará una bronconeumonía por ventilación mecánica.
Quizá por eso los intubados tienen mal pronóstico, aparte no les dan tratamiento.
En eso se ha convertido la ciencia moderna. Una desgracia.
Quizá por eso los intubados tienen mal pronóstico, aparte no les dan tratamiento.
En eso se ha convertido la ciencia moderna. Una desgracia.
Se me olvidó mencionarles que en esta imagen podemos observar el momento exacto donde un leucocito libera sus granulaciones toxicas sobre los eritrocitos infectados.
Para los que no saben, así es como luce nuestra sangre en un microscopio los círculos rojos son los glóbulos rojos, los puntos rosados son plaquetas y las células más grandes son glóbulos blancos.
La sangre se tiñe con colorantes especiales, por eso de ven de estos colores.
La sangre se tiñe con colorantes especiales, por eso de ven de estos colores.
Yo ocupo la tincion de May-Grünwald Giemsa para buscar hemoparasitos.
Los puntos o inclusiones de color morado dentro de los glóbulos rojos/eritrocitos son hemoparasitos.
Se darán cuenta que son diferentes porque siempre hay co-infecciones, es decir, dos o más parásitos.
Los puntos o inclusiones de color morado dentro de los glóbulos rojos/eritrocitos son hemoparasitos.
Se darán cuenta que son diferentes porque siempre hay co-infecciones, es decir, dos o más parásitos.
En la mayoría de los casos de COVID-19 el parásito que suele observarse es Mycoplasma.
Estás 4 imágenes son de manuales de veterinaria, podemos observar sangre infectada por Mycoplasma.
Estás 4 imágenes son de manuales de veterinaria, podemos observar sangre infectada por Mycoplasma.
Ahora estás 4 imágenes las tome yo, de 4 pacientes con COVID-19 que estuvieron intubados en terapia intensiva.
Tengo una lista de casi 100 pacientes con COVID a los que les he tomado muestras y TODOS tienen lo mismo.
Los pacientes se mueren porque no es el diagnóstico correcto.
Todo gracias a la Organización Mundial de la Salud que financia Bill Gates.
En pleno 2020.
Los pacientes se mueren porque no es el diagnóstico correcto.
Todo gracias a la Organización Mundial de la Salud que financia Bill Gates.
En pleno 2020.
Y lamento informar a todos aquellos que salieron de alta del hospital, tarde o temprano volverán a presentar los mismos síntomas.
Estas infecciones son tratadas por años o de por vida, no puedes matarlos porque están dentro de tus eritrocitos y ellos transportan oxígeno.
Estas infecciones son tratadas por años o de por vida, no puedes matarlos porque están dentro de tus eritrocitos y ellos transportan oxígeno.
Si te falta el aire es por eso, no por un pinche coronavirus indefenso.
Se aprovechan de la ignorancia de la población, incluidos los médicos, si ninguno conoce los Mycoplasmas jamás podría diagnosticar correctamente.
Para eso estámos los Químicos y el Laborstorio.
Se aprovechan de la ignorancia de la población, incluidos los médicos, si ninguno conoce los Mycoplasmas jamás podría diagnosticar correctamente.
Para eso estámos los Químicos y el Laborstorio.
Pero ya ellos decidieron que van a diagnosticar con Rayos X porque las pruebas diagnósticas no sirven.
Como si viviéramos en pleno 1876.
Ya mejor que den consulta por teléfono, ahhh no, ya lo están haciendo.
Maravillas de la ciencia moderna.
Como si viviéramos en pleno 1876.
Ya mejor que den consulta por teléfono, ahhh no, ya lo están haciendo.
Maravillas de la ciencia moderna.
Y de preguntarán cómo es que todos tienen parásitos en la sangre. Bueno eso es fácil, Mycoplasma es el microorganismo por excelencia en contaminar las vacunas y medios de cultivo donde se desarrollan con mucha “seguridad” las vacunas.
Repitan conmigo.
Las vacunas no son efectivas ni seguras.
Apuesto mi Título Profesional de Química Clínica contra el de cualquier doctor que me compruebe que son seguras.
O que explique cómo hay contaminantes en las vacunas que son tan seguras.
Las vacunas no son efectivas ni seguras.
Apuesto mi Título Profesional de Química Clínica contra el de cualquier doctor que me compruebe que son seguras.
O que explique cómo hay contaminantes en las vacunas que son tan seguras.
El Dr. Garth Nicolson ha estudiado a estos organismos desde hace años.
En este video habla de cómo infectaron a los militares de la Guerra del Golfo con Mycoplasma a través de la vacunación.
Busquen la enfermedad de la Guerra del Golfo. https://youtu.be/sT25HhAVhhU ">https://youtu.be/sT25HhAVh...
En este video habla de cómo infectaron a los militares de la Guerra del Golfo con Mycoplasma a través de la vacunación.
Busquen la enfermedad de la Guerra del Golfo. https://youtu.be/sT25HhAVhhU ">https://youtu.be/sT25HhAVh...
También explica la relación de mycoplasma con autismo, esclerosis lateral amiotrofica, esclerosis múltiple y básicamente cada una de las enfermedades crónicodegenerativas o autoimmunes en la actualidad están relacionadas con parásitos sanguíneos.
También habla de la facilidad con la que insertan genes específicos para volver más infeccioso o resistente a este microorganismo.
Mycoplasma es Arma Biológica de destruccion masiva, afirma el doctor Nicholson.
Así que no es algo nuevo que la OMS no pueda imaginarse o saber.
Mycoplasma es Arma Biológica de destruccion masiva, afirma el doctor Nicholson.
Así que no es algo nuevo que la OMS no pueda imaginarse o saber.
Por eso la hidroxicloroquina, azitromicina e Ivermectina ayudan en COVID-19 porque hay infección por Mycoplasmas.
Yo tengo como comprobar qué hay parásitos en los pacientes y hasta la fecha nadie ha podido aislar un Coronavirus de algún paciente.
¿Donde quedó la ciencia?
Yo tengo como comprobar qué hay parásitos en los pacientes y hasta la fecha nadie ha podido aislar un Coronavirus de algún paciente.
¿Donde quedó la ciencia?
La enfermedad de la Guerra del Golfo causada por Mycoplasmas estuvo asociada a los esquemas de vacunacion múltiple o contaminación por aire.
A esta Arma Biológica se le insertan genes para que resistan cualquier temperatura y terreno pero sobretodo para burlar al sistema inmune.
A esta Arma Biológica se le insertan genes para que resistan cualquier temperatura y terreno pero sobretodo para burlar al sistema inmune.
Aquí está el trabajo de Nicolson en PDF.
https://www.researchgate.net/profile/Garth_Nicolson/publication/13651853_Gulf_War_illnesses_Complex_medical_scientific_and_political_paradox/links/0912f5140cad030249000000/Gulf-War-illnesses-Complex-medical-scientific-and-political-paradox.pdf?origin=publication_detail">https://www.researchgate.net/profile/G...
https://www.researchgate.net/profile/Garth_Nicolson/publication/13651853_Gulf_War_illnesses_Complex_medical_scientific_and_political_paradox/links/0912f5140cad030249000000/Gulf-War-illnesses-Complex-medical-scientific-and-political-paradox.pdf?origin=publication_detail">https://www.researchgate.net/profile/G...
Entonces tenemos al COVID-19.
Un síndrome causado por las vacunas y que como siempre, està planeado desde hace mucho.
Si pierdes el gusto y el olfato o te zumba el oído, no tienes coronavirus, tienes una deficiencia de Zinc. Ingiriendo Zinc todo vuelve a la normalidad.
Un síndrome causado por las vacunas y que como siempre, està planeado desde hace mucho.
Si pierdes el gusto y el olfato o te zumba el oído, no tienes coronavirus, tienes una deficiencia de Zinc. Ingiriendo Zinc todo vuelve a la normalidad.
El zinc compite por las células con los metales pesados, de este modo las celulas no logran absorber todo el zinc que ingerimos. Cada 6 meses nos inyectan mercurio en la vacuna de la Influenza.
Ya se que la OMS dice que el Thiomerosal no es peligroso y es seguro inyectarlo cada 6 meses a toda la población, incluyendo recién nacidos y embarazadas porque son cantidades mínimas que diario ingerimos en pescado o Chemtrails, así que no importa que sea inyectado en humanos.
Pero yo prefiero que algo que el mismo fabricante considera tóxico o mortal si se ingiere no se lo inyecten a mis hijos.
Aclaro que es mi pensar, no sé ustedes qué opinen de algo que puede dañar los órganos tras la exposición prolongada. Y se administre cada 6 a todo el mundo.
Aclaro que es mi pensar, no sé ustedes qué opinen de algo que puede dañar los órganos tras la exposición prolongada. Y se administre cada 6 a todo el mundo.
También creo conveniente no experimentar con mi esposa en caso de que estuviera embarazada cuando la OMS menciona que no hay datos de seguridad en la administración de vacunas en embarazadas.
Es mi humilde opinión. No se ustedes.
Es mi humilde opinión. No se ustedes.
No todos, pero en la mayoría de los niños autistas encontramos niveles altos de mercurio y aluminio.
Cuando la OMS dice que no hay datos de que la cantidad inyectada es dañina o lo minimizan diciendo que la comida y agua también tienen mercurio, de burlan de nosotros.
Cuando la OMS dice que no hay datos de que la cantidad inyectada es dañina o lo minimizan diciendo que la comida y agua también tienen mercurio, de burlan de nosotros.
Cuando un producto es tan tóxico como el mercurio, no existen pruebas de cuánto daña y cuánto NO daña, por eso no hay datos, no porque no haga daño.
Es tan tóxico que ni siquiera existe un mínimo ya que NO debería ser usado en humanos o animales por su toxicidad.
Es tan tóxico que ni siquiera existe un mínimo ya que NO debería ser usado en humanos o animales por su toxicidad.
Y al decir que en alimentos consumimos más mercurio se burlan de nuevo.
Que les dice su médico cuando no quieren una inyección. Una inyección es mejor porque todo el medicamento pasa al torrente sanguíneo. Al ingerir pastillas o comer el intestino filtra y la absorción es menor
Que les dice su médico cuando no quieren una inyección. Una inyección es mejor porque todo el medicamento pasa al torrente sanguíneo. Al ingerir pastillas o comer el intestino filtra y la absorción es menor
Entonces mercurio inyectado es mucho peor que mercurio ingerido en comida, básicamente no hay comparación. Tomando en cuenta que no se elimina, entonces se acumula en nuestro cuerpo.
Si no se acumulará no existirían los tratamientos para quelar metales pesados.
Si no se acumulará no existirían los tratamientos para quelar metales pesados.
¿Podemos confiar en lo que dice la OMS?
Todavía tienen el descaro de poner DEMOSTRADO.
La Hidroxicloroquina, Ivermectina y Azitromicina son los antiparásitarios que están salvando a los pacientes más graves.
Ahora si muy preocupados por la salud de la población pero cada 6 meses les inyectan mercurio a todos.
La Hidroxicloroquina, Ivermectina y Azitromicina son los antiparásitarios que están salvando a los pacientes más graves.
Ahora si muy preocupados por la salud de la población pero cada 6 meses les inyectan mercurio a todos.
Claro qué hay tratamiento.
Este es el tratamiento de conocido Neumólogo mexicano.
Hidroxicloroquina, ivermectina y Azitromicina.
Eluquis es igual de importante porque impide la formación de trombos que pudieran provocar una tromboembolia pulmonar.
Este es el tratamiento de conocido Neumólogo mexicano.
Hidroxicloroquina, ivermectina y Azitromicina.
Eluquis es igual de importante porque impide la formación de trombos que pudieran provocar una tromboembolia pulmonar.
Lo único malo es que a pesar de que el médico se da cuenta de que algo anda mal, no sabe qué son hemoparasitos. Solo sabe que sirven y los receta, en 2 meses el paciente volverá porque los parásitos seguirán infectando sus células. Y ahí tendremos la famosa REINFECCION.
Thalía tiene años en tratamiento para Borreliosis, la co-infección más documentada de Mycoplasmosis, también se le da el nombre de Hemobartonela.
Así que por ahorita enmascaran el problema cuando lo peor apenas está por venir.
Así que por ahorita enmascaran el problema cuando lo peor apenas está por venir.
Y me comentan que no sé nada de biología jajajajaja entonces todos los que si entendemos como funcionan las cosas somos los pendejos y los que solo repiten lo que se les dice son los que saben todo de la enfermedad.
Fake science.
¿Así o más claro? Ojo, salvan a los pacientes pero regresarán porque no es un virus es un parásito como en la Malaria o Paludismo.
De ahí viene el desprestigio por parte de los medios de comunicación asociandola con Trump y conspiraciones.
Qué más podrían hacer después de que tantos nos damos cuenta del genocidio de la OMS.
Qué más podrían hacer después de que tantos nos damos cuenta del genocidio de la OMS.
Y claro que no hay libertad de expresión. Facebook censurando la cura porque podría ser peligroso y recomendando seguir las instrucciones de la OMS jajajajaja ya que más pruebas quieren.
Aquí les dejo el estudio de hace 15 años.
https://www.ncbi.nlm.nih.gov/pmc/articles/PMC1232869/
¿Realmente">https://www.ncbi.nlm.nih.gov/pmc/artic... creen que la OMS no lo sabe?
https://www.ncbi.nlm.nih.gov/pmc/articles/PMC1232869/
¿Realmente">https://www.ncbi.nlm.nih.gov/pmc/artic... creen que la OMS no lo sabe?
Para los expertos que afirman que no sé nada y que me ponga a estudiar ruego me expliquen que son estás inclusiones eritrocitarias si no son hemoparasitos.
La tincion y colorantes están perfectos así que no va por ahí.
La tincion y colorantes están perfectos así que no va por ahí.
También encontré levaduras de Histoplasma Capsulatum en pacientes COVID, en las primeras imágenes se ven las levaduras en sangre periférica y en la última vemos un neutrófilo que ha fagocitado levaduras de Histoplasma.
O
O
O
El paciente falleció gracias a un mal diagnóstico, porque actualmente todo es COVID-19 y los médicos diagnostican con una tele de tórax y da la casualidad que alguien con histoplasmosis o COVID presentan el mismo infiltr elado bilateral difuso.
Alguien con tuberculosis o infección por Rikettsia igual podría ser diagnosticado con COVID unicamente con estudio radiológico.
El problema no es que te diagnostiquen con COVID, el problema es que no les dan tratamiento oportuno y lamentablemente el pronóstico es malo.
El problema no es que te diagnostiquen con COVID, el problema es que no les dan tratamiento oportuno y lamentablemente el pronóstico es malo.
Ya no hay influenza, ya no hay EPOC, ni cardiopatias congestivas, es más no puedes comer nada que pueda provocarte diarrea porque automáticamente tienes COVID.
TODOS TENEMOS COVID HASTA QUE SE DEMUESTRE LO CONTRARIO.
TODOS TENEMOS COVID HASTA QUE SE DEMUESTRE LO CONTRARIO.
Por eso los vídeos de familiares diciendo que los médicos están matando a la gente.
Literalmente si, pero no es intencional, ellos creen que hacer lo que la OMS dice es lo correcto. No están usando su criterio solo siguen "el protocolo".
Literalmente si, pero no es intencional, ellos creen que hacer lo que la OMS dice es lo correcto. No están usando su criterio solo siguen "el protocolo".
Y si alguno se da cuenta no puede cambiar nada porque sus jefes lo impiden por órdenes de más arriba.
¿Quien lleva la mayoría de casos COVID?
ISSSTE, IMSS, PEMEX, SEDENA y Secretaría de Salud.
Son hospitales del gobierno.
¿Quien lleva la mayoría de casos COVID?
ISSSTE, IMSS, PEMEX, SEDENA y Secretaría de Salud.
Son hospitales del gobierno.
Los jefes reciben órdenes y protocolos estandarizados que emite el CDC con lineamientos de la OMS.
Esto significa que todos siguen el mismo protocolo. Entiendas o no entiendas, te guste o no te guste sigues el mismo protocolo incluso dándote cuenta que está mal lo debes hacer.
Esto significa que todos siguen el mismo protocolo. Entiendas o no entiendas, te guste o no te guste sigues el mismo protocolo incluso dándote cuenta que está mal lo debes hacer.
Si quieres conservar tu trabajo, claro.
Olvidemos que son medicos, van a trabajar para ganar dinero como cualquiera de nosotros.
¿Cuantos de nosotros quisiéramos perder nuestro trabajo?
Nadie está dispuesto a perder su trabajo por 3ras personas, no importa la profesión.
Olvidemos que son medicos, van a trabajar para ganar dinero como cualquiera de nosotros.
¿Cuantos de nosotros quisiéramos perder nuestro trabajo?
Nadie está dispuesto a perder su trabajo por 3ras personas, no importa la profesión.
En conclusión está planeado como todo.
No es un virus ya que no tendría cura. Si tiene cura no es un virus.
Niegan la cura. Para vender la vacuna.
¿Vacuna para qué? ¿Para hemoparasitos?
No es un virus ya que no tendría cura. Si tiene cura no es un virus.
Niegan la cura. Para vender la vacuna.
¿Vacuna para qué? ¿Para hemoparasitos?
Para los que pidieron videos, claro que son hemoparasitos, seguimos recibiendo pacientes COVID-19 y TODOS sin excepción tienen parásitos en sangre para ser exactos Babesia (en el video), Mycoplasma, Histoplasma Capsulatum, Hemobartonella y Rikettsia.
¿Cuando en toda la historia de la humanidad un virus respiratorio había ocacionado tantos síntomas?
Estas son las consecuencias de diagnosticar en base a síntomas y no a pruebas diagnosticas.
Estas son las consecuencias de diagnosticar en base a síntomas y no a pruebas diagnosticas.
Todos estos síntomas los presenta alguien infectado con hemoparasitos ya que el principal objetivo de estos microorganismos es el sistema inmune y el sistema nervioso autónomo o vegetativo.
Aquí pueden leer un poco. https://psicologiaymente.com/neurociencias/sistema-nervioso-autonomo">https://psicologiaymente.com/neurocien...
Aquí pueden leer un poco. https://psicologiaymente.com/neurociencias/sistema-nervioso-autonomo">https://psicologiaymente.com/neurocien...
Es vital para que todos nuestros órganos cumplan sus funciones adecuadamente.
Por eso la falla multiorgánica y datos de neuropatías que vemos en pacientes COVID-19 por eso no funciona la intubación que la OMS recomienda.
Por eso la falla multiorgánica y datos de neuropatías que vemos en pacientes COVID-19 por eso no funciona la intubación que la OMS recomienda.
El daño en el SNA se conoce como Disautonomía y afecta a 70 millones de personas.
No veo a nadie de la OMS y los gobiernos cuidando de nosotros la como nos cuida del COVID.
Ah, es que ahí no pueden vender vacunas ni medicamentos patentados Big Pharma.
No veo a nadie de la OMS y los gobiernos cuidando de nosotros la como nos cuida del COVID.
Ah, es que ahí no pueden vender vacunas ni medicamentos patentados Big Pharma.
Googleen síntomas de Babeiosis humana, de Mycoplasmosis y de Hemobartonella, informe se porque seguramente ustedes también tienen.
Ahora díganme si consideran real que un "coronavirus" esté ocacionado estos síntomas y que la explicación científica sea que son "atípicos".
Ahora díganme si consideran real que un "coronavirus" esté ocacionado estos síntomas y que la explicación científica sea que son "atípicos".
Seguimos dándole sin miedo al éxito. Les platicaré, aparte de los parásitos intracelulares, qué otras peculiaridades encontramos en pacientes COVID-19.
Tal y como lo mencioné antes, las celulas sanguíneas se dividen en tres estirpes -glóbulos rojos o eritrocitos- transportan oxígeno y hemoglobina, -glóbulos blancos o leucocitos- son las células del sistema inmune y las -plaquetas- que son papel fundamental de la coagulacion.
Estos microorganismos impiden el correcto transporte de oxígeno y sintesis de hemoglobina que llevan a cabo los eritrocitos, afecta morfológicamente a los leucocitos y promueve la adhesión celular provocando la Coagulación Intravascular Diseminada. Eritrocitos en Rouleaux.
Cuando lo normal es así, juntas pero sin tocarse y las plaquetas solas y sin agruparse gracias al potencial "Z" de las células y sus fuerzas electrostáticas.
En cuanto a la morfología de los eritrocitos encontramos abundantes leptositos, codocitos, esferocitos y dacriocitos, propios de Anemia por deficiencia de hierro, anemia megaloblástica o anemia hemolitica pero SIN anemia.
El paciente no tiene anemia, pero su eritrocitos tienen las características morfológicas de una deficiencia de hierro. Significa que los eritrocitos no están transportando suficiente hemoglobina por algún motivo diferente a la deficiencia de hierro, el motivo es la Babesia.
Por este motivo es que la Ferritina se eleva tanto en pacientes COVID. Pregúntenle a algún médico para qué piden Ferritina si nunca la ocupan en neumonías atípicas; solo la piden para valorar la evolución, entre más alta peor es el pronóstico del paciente.
¿Porqué? Cómo dice este documento, lo asocian con la inflamación y producción de citoquinas y ya.
La realidad es otra y les será muy fácil saber en qué patología encontramos los niveles de Ferritina.
La realidad es otra y les será muy fácil saber en qué patología encontramos los niveles de Ferritina.
Correcto.
Niveles muy elevados de Ferritina como marcador diagnóstico de Babesia en humanos.
Si se dan cuenta la tabla muestra los datos de laboratorio al ingresar.
Niveles muy elevados de Ferritina como marcador diagnóstico de Babesia en humanos.
Si se dan cuenta la tabla muestra los datos de laboratorio al ingresar.
Los leucocitos que nos defienden de parásitos son los Eosinofilo. Observamos como liberan sus granulaciones sobre los eritrocitos infectados comprobando la presencia de parásitos.
Sus exámenes de laboratorio concuerdan con un síndrome de montaña o una anemia hemolítica microangiopatica. Pero no para pensar en una Neumonia y menos cuando hay Coagulación Intravascular Diseminada. A menos que la OMS diga lo contrario, incluso siendo imposible.
Con decirles que jamás nadie ha aislado a el SARS-COV 2. No les voy a decir que no existe porque si existen miles de Coronavirus pero ninguno tiene la capacidad biológica de producir esto que vivimos en México. No puedo asegurar que sea igual en otros países.
Lo que sí puedo asegurar es que sí hubo mejoría utilizando cloroquina, ivermectina o azitromicina hay un 99% de probabilidad de que también sean hemoparasitos.
Por otro lado como lo he mencionado desde el principio en China, España, Italia y demás países dónde se ha implementado la red 5G hemos visto los mismos síntomas inespecíficos del supuesto CPVID.
NOD
NOD
Específicamente los campos electromagnéticos son los que nos afectan, no la antena. Y no digo que transmitan el virus, simplemente la gente afectadA tiene problemas para respirar y si los médicos diagnostican con síntomas pues claro que coinciden con los síntomas de COVID.

 Read on Twitter
Read on Twitter